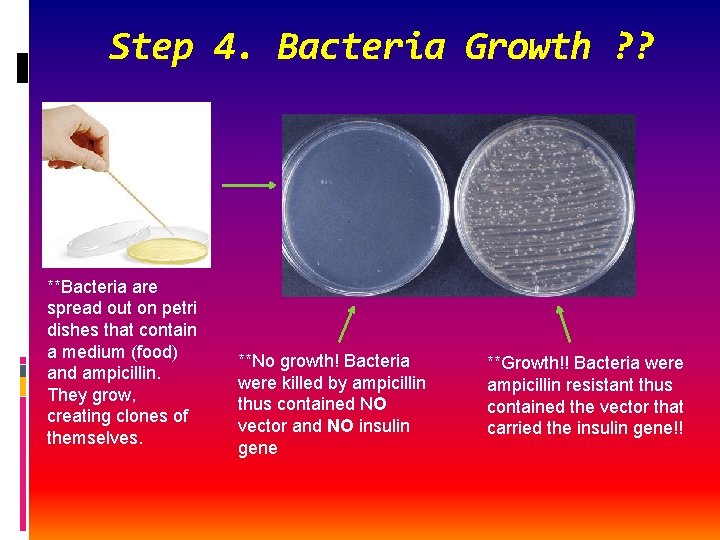
Step 4. Bacteria Growth ? ? **Bacteria are spread out on petri dishes that

BACTERIAL TRANSFORMATION Genetically Engineered Bacteria Its basically how

BACTERIAL TRANSFORMATION

Genetically Engineered Bacteria It’s basically how scientists and researchers manipulate genes from one species into the genome of a bacterium Recall, DNA is the genetic material of all living organisms that carry genetic code that may code for proteins. In this case, a genes from one kind of organism can be transcribed and translated (protein synthesis!) when inserted into a host bacteria. . . as bacteria continuously divide, the protein is continuously produced For example, human genes are routinely put into bacteria in order to synthesize products for medical treatment. Human insulin for diabetics, human growth hormone to treat people of short stature caused by a known medical/genetic condition, and vaccines

First, What is……………… • Recombinant DNA from different sources “sliced then spliced” together (e. g. human gene inserted into a bacterium plasmid) • Called a transgenic organism • Plasmid Vector Circular, double-stranded DNA used to transfer foreign genes into a host bacterium • Bacterial Transformation Occurs when a host bacterium, such as E. coli, takes up a plasmid that has been engineered to contain a foreign gene. • Restriction Enzymes proteins that digest DNA at specific regions for preparation of bacterial transformation • DNA Ligase type of enzymes that reform hydrogen bonds between nucleotide pair

**Here’s a simple depiction of how human insulin is produced using bacteria ** The bacteria E. coli is the most common bacteria used to produce synthetic human insulin **Look at numbers 1 -4 in the illustration. Notice the terminology!

Bacterial Transformation *This process is pretty involved, but here’s the basic idea. We’ll use the production of human insulin as an example.

Let’s Look at Restriction Enzymes for The First Step CTTAAG Backwards ** These enzymes recognize a very specific, single palindrome nucleotide sequence. Eco. RI CTTAAG Forwards ** Palindromes are sequences that are the same forwards as they are backwards…like the word racecar

Step 1: A Restriction Enzyme Cleaves The Plasmid and Target Gene Restriction enzyme recognizes nucleotide sequence specific to that enzyme When it recognizes the palindrome, it cuts the DNA Restriction Enzyme ACTCGCGGAATTCATTACGCATCG TGAGCGCCTTAAGTAATGCGTAGC Eco. RI **The black letters represent the palindrome recognition site ACTCGCGG AATTCATTACGCATCG TGAGCGCCTTAA GTAATGCGTAGC ** “Sticky” ends are created (the black letters) that stick out. This allows a gene, or other segment of DNA, to be inserted by base-pairing

Step 2. Inserting the Gene Into Bacterial Plasmid Vector The human insulin gene is inserted at the “Sticky” ends of the plasmid at the palindrome through base -pairing DNA ligase “glues” (ligates) them together ACTCGCGG Ligase AATTCATTACGCATCG TGAGCGCCTTAA GTAATGCGTAGC **The black letters represent the binding site of the plasmid. The white is plasmid DNA GAATTCGGTATCGCCTACCCG AATTC CTTAAGCCATAGCGGATGGGCTTAAG **The yellow nucleotides represent the gene for human insulin (of course it is much larger than this, but you get the idea!).

Step 3. Host Cell (E. coli here) Takes Up The Plasmid Vector *NOTICE…Plasmid vector also carries a gene that makes them resistant to ampicillin, an antibiotic that kills bacteria!! This is important in the next step, cloning and the production of insulin!!
Step 4. Bacteria Growth ? ? **Bacteria are spread out on petri dishes that contain a medium (food) and ampicillin. They grow, creating clones of themselves. **No growth! Bacteria were killed by ampicillin thus contained NO vector and NO insulin gene **Growth!! Bacteria were ampicillin resistant thus contained the vector that carried the insulin gene!!

Step 5. Collecting Cloned Product **Colonies that contain plasmid vector are allowed to grow, cloning themselves. As they do so, insulin is produced as the human gene is expressed (remember transcription and translation aka protein synthesis!!) **Eventually, the crude protein can be extracted, purified and you’ve got insulin! **This is done on a much wider scale than we’ve learned here. Pharmaceutical companies produce enough insulin for millions of Americans who have insulindependent diabetes.

In Summary……

Did You know…………. . Approximately 3, 000 restriction enzymes, recognizing over 230 different DNA sequences, have been discovered (Mostly in bacteria) over the past 30 years! Also called endonucleases, some of these enzymes cleave to create blunt ends (not sticking out). In this case, commercial cloning kits are typically used to ligate ends of known nucleotide sequences so target DNA can recognize a site for cloning Restriction enzymes are also used to create DNA fingerprints unique to you! DNA is cut at areas, not associated with genes, that have repeats such as AGGTAGGT, over and over but the number of repeats differ among people. We can run these on a gel (CSI stuff) and see their DNA fingerprint! These can be used to determine paternity…we’ll look at this soon!!
- Slides: 13